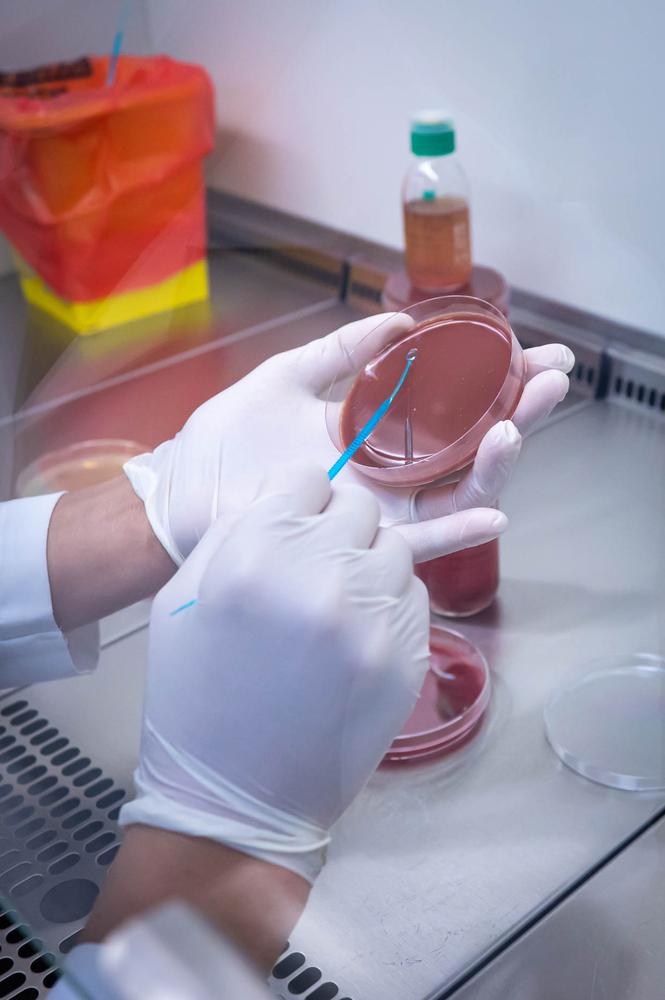
Manual culture-based analysis of a blood sample

Antimicrobial Resistance in Kinshasa: Innovation & Advocacy
Antimicrobial resistance (AMR) is a silent pandemic threatening life worldwide. In Kinshasa, Democratic Republic of Congo (DRC), Médecins sans Frontières (MSF) is leading initiatives to tackle this crisis head-on, especially at Kabinda hospital, where MSF treats people living with HIV. In last November, Dr. Pilar Garcia-Vello performed a field visit to coordinate research, strengthen laboratory practices, and advocate for support.
From Diagnosis to Data
Kinshasa has one of MSF’s most advanced microbiology and molecular laboratories, enabling accurate pathogen identification, antimicrobial susceptibility testing, and AMR surveillance. The laboratory is integrated with Infection Prevention and Control (IPC) and Antimicrobial Stewardship (AMS) programs, and operates in collaboration with the Ministry of Health – forming a comprehensive, cross-sectional AMR intervention.
In this context, numerous research projects are happening:
- Carba 5 evaluation. Carba5 is a rapid assay to detect the most common carbapenemase enzymes, which make bacteria resistant to strong antibiotics (the carbapenems). Identifying the mechanisms of resistance of bacteria are a critical for surveillance and designing AMR responses. MSF is checking if this kind of assays are feasible to be used in humanitarian settings. Results to be shared soon!
- MinION sequencing dives into bacterial genetics, and MSF is using it to trace past outbreaks and study transmission dynamics and inform future strategies. Implementation is just weeks away.
- New antimicrobials implementation, with all of this epidemiological information, new antimicrobials, currently unavailable in DRC will be introduced and their impact on patient outcomes studied. Our patients will have access to the treatment they deserve, while we build strong evidence to advocate for the affordability and availability of essential antimicrobials.

Retrospective Analysis and Candidemia: Lessons from the Frontline
Candidemia is a bloodstream infection caused by Candida species and remains a serious health concern, often difficult to diagnose and treat. This study examines patient cases to identify affected populations, diagnostic barriers, and treatment patterns, providing insights into areas for improvement in clinical management and advocate for diagnosis accessibility.
In parallel, an analysis of the Point Prevalence Surveys (PPS) of the last years was conducted to evaluate antimicrobial prescribing practices. The analysis of PPS over time also will allow the evaluation of the impact of different events had on the presciptionprescription practices. Optimizing these practices is essential to reduce antimicrobial misuse and improve patient outcomes.
Why Research Matters
AMR poses an existential threat to global health, yet research often neglects high burden contexts where the means to address AMR are most limited. MSF puts the most vulnerable patients at the center of its research. This is the case of patients living with HIV at the Kabinda hospital, with contextualised equity-driven research. Advancing MSF’s research priorities on AMR is not only critical for improving patient outcomes in humanitarian settings but is also essential to safeguard the effectiveness of antimicrobials for everyone.